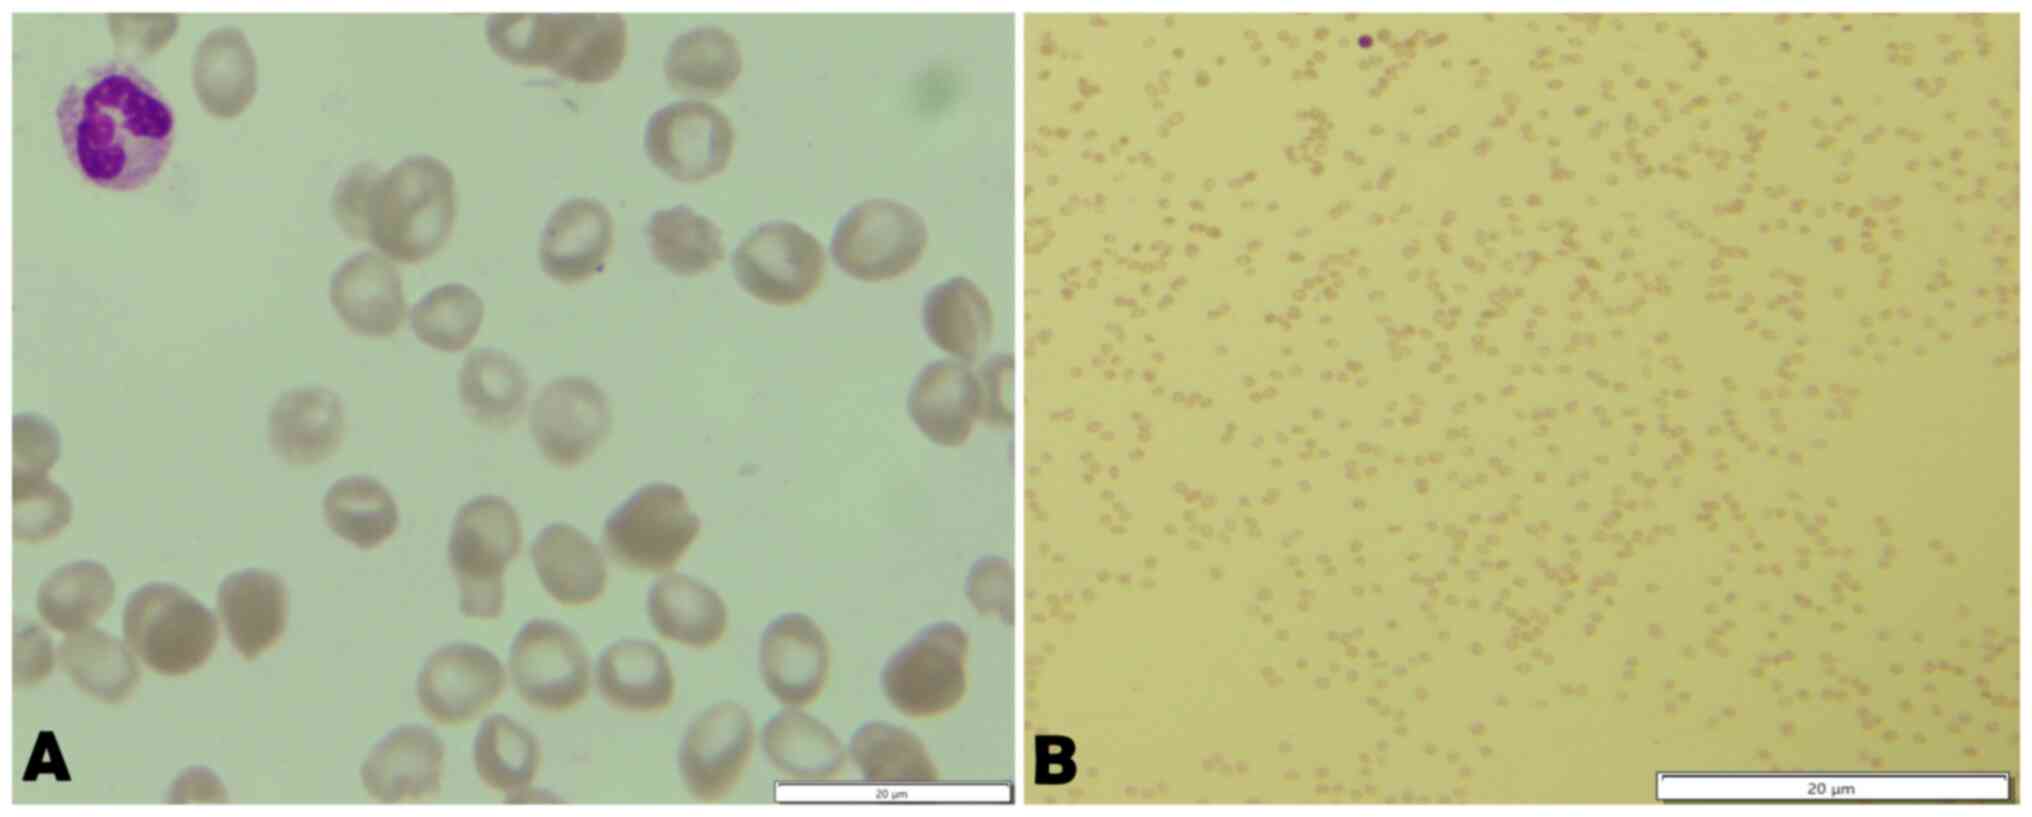

Introduction
Chronic myeloid leukemia (CML) is a
myeloproliferative neoplasm driven by the Philadelphia chromosome,
resulting from a reciprocal translocation between chromosomes 9 and
22, and forming the breakpoint cluster region (BCR)-Abelson
tyrosine kinase 1 (ABL1) fusion gene (1). This fusion gene encodes constitutively
active tyrosine kinases, making it a key therapeutic target for
inhibitors such as imatinib, which is used as frontline therapy.
However, mutations in the BCR-ABL1 tyrosine kinase domain (TKD)
cause imatinib resistance in the majority of patients with CML and
remain a notable challenge (2,3). The
global incidence of CML is 1–2 cases per 100,000 adults,
representing 15% of newly diagnosed leukemia cases in adults
(4). Notably, ~50% of patients with
CML lack typical symptoms in the early stage and are often
incidentally discovered through routine physical examinations or
blood tests. Bone marrow biopsy is the gold standard for confirming
hyperplasia of bone marrow cells and abnormal maturation of the
myeloid cell line. Molecular diagnosis relies on the detection of
the BCR-ABL1 fusion gene, which can be identified through the
translocation of chromosomes t(9;22)(q34;q11) using fluorescence
in situ hybridization or quantitative PCR (qPCR) (5). Identifying novel or concomitant
mutations that contribute to resistance is critical for optimizing
therapeutic strategies and improving patient outcomes. The
threonine-to-isoleucine substitution at position 315 (T315I) is
responsible for ~20% of clinical resistance cases in imatinib-naïve
patients with CML (6). The
prognosis of CML has significantly improved with the application of
tyrosine kinase inhibitors (TKIs), with the 5-year survival rate
increasing from 50 to >90% (7).
However, ~9% of patients may progress to blast crisis or
accelerated phase, leading to a sharp reduction in survival.
Regular assessment of hematological, cytogenetic and molecular
indicators is necessary to monitor treatment response (8). The glutamic acid-to-lysine
substitution at position 459 (E459K) has been described in a
limited number of CML cases (9,10), and
its role in disease progression and resistance to TKIs remains
poorly understood. The present report describes a patient with CML
harboring both T315I and E459K mutations.
Case report
In June 2024, a 57-year-old woman presented to the
Department of Orthopedic Oncology with a history of right upper arm
pain and restricted mobility of the right shoulder joint lasting
>4 months. The patient had a 7-year history of CML and had
achieved complete molecular remission after 6 years of regular
imatinib therapy. However, the patient had discontinued treatment
and follow-up 1 year prior to the current admission. Upon
admission, laboratory examination revealed a white blood cell count
of 44.70×109/l, a hemoglobin level of 105 g/l and a
platelet count of 1,195×109/l (Table I). Bone marrow aspiration confirmed
CML in the chronic phase, with BCR-ABL1 p210 positivity and no
detectable TKD mutations.
 | Table I.Laboratory results in June 2024. |
Table I.
Laboratory results in June 2024.
| Laboratory
results | Value (reference
range) |
|---|
| White blood cell
count, n ×109/l | 44.7
(4.0–10.0) |
| Red blood cell
count, n ×1012/l | 3.83 (4.1–5.2) |
| Hemoglobin,
g/l | 105 (115–150) |
| Hematocrit, % | 32.60 (36–44) |
| Platelet count, n
×109/l | 1,195
(150–400) |
| Lymphocyte absolute
count, n ×109/l | 3.17 (1.0–3.0) |
| Monocyte absolute
count, n ×109/l | 1.16 (0.2–1.0) |
| Neutrophil absolute
count, n ×109/l | 28.89
(2.0–7.0) |
| Aspartate
aminotransferase, U/l | 13 (10–40) |
| Alkaline
phosphatase, U/l | 129 (30–120) |
| RDW-coefficient of
variation, % | 16.10
(11.5–14.5) |
| RDW-standard
deviation, fl | 51 (39–46) |
| Mean platelet
volume, fl | 8.50
(7.5–11.5) |
| Platelet-large cell
ratio, fl | 18.10 (13–43) |
| Glucose,
mmol/l | 13.27
(3.9–6.1) |
| Lactate
dehydrogenase, U/l | 576.10
(125–220) |
Imaging studies indicated malignancy in the right
humerus, with computed tomography revealing bone destruction in the
upper to mid humerus and localized lytic lesions in the scapula.
Magnetic resonance imaging (MRI) demonstrated proximal humerus
cortical disruption, heterogeneous signal intensities and
surrounding soft-tissue masses with mixed high and low
fat-suppressed T2-weighted imaging signals, consistent with a
malignant process (Fig. 1A and B).
The patient was started on dasatinib (100 mg once daily), with
recommendations for regular blood count monitoring and surgical
intervention after disease control. After 1 month of treatment, the
patient achieved complete hematological remission, with notable
improvement in arm pain. However, a biopsy was not performed during
this period.
The patient continued dasatinib therapy but
presented to the hospital again in November 2024, with fatigue and
petechiae on the lower limbs. Laboratory evaluations revealed
severe pancytopenia, with a hemoglobin level of 60 g/l, a white
blood cell count of 1.55×109/l and a platelet count of
11.00×109/l (Table
II).
 | Table II.Laboratory results in November
2024. |
Table II.
Laboratory results in November
2024.
| Laboratory
results | Value (reference
range) |
|---|
| White blood cell
count, n ×109/l | 1.55l
(4.0–10.0) |
| Red blood cell
count, n ×1012/l | 2.02 (4.1–5.2) |
| Hemoglobin,
g/l | 60 (115–150) |
| Hematocrit, % | 18.40%
(36–44%) |
| Platelet count, n
×109/l | 11.00
(150–400) |
| Lymphocyte absolute
count, n ×109/l | 0.71 (1.0–3.0) |
| Monocyte absolute
count, n ×109/l | 0.09 (0.2–1.0) |
| Neutrophil absolute
count, n ×109/l | 0.73 (2.0–7.0) |
| Aspartate
aminotransferase, U/l | 8 (10–40) |
| Alkaline
phosphatase, U/l | 148 (30–120) |
| RDW-coefficient of
variation, % | 19.40
(11.5–14.5) |
| RDW-standard
deviation, fl | 62.40 (39–46) |
| Mean platelet
volume, fl | 7.20
(7.5–11.5) |
| Platelet-large cell
ratio, fl | 7.70 (13–43) |
| Glucose,
mmol/l | 7.33 (3.9–6.1) |
| Lactate
dehydrogenase, U/l | 278.40
(125–220) |
Dasatinib was discontinued, and the patient
subsequently received a transfusion of 2 units of
leukocyte-depleted red blood cells and 1 therapeutic dose of
platelets. Cytological examination of the bone marrow smear
demonstrated notable hypoplasia and dilution (Fig. 2). Smears were stained with
Wright-Giemsa stain for 15–20 min at room temperature (18–25°C),
followed by rinsing and air-drying. Morphological analysis was
performed under an Olympus BX53 optical microscope equipped with
100X oil immersion objectives, with digital image acquisition and
cell quantification conducted using Motic DS Assistant v2.0
software (Motic China Group Co., Ltd.), revealing a
granulocyte-to-erythroid ratio of 6.57:1. Both granulocytic and
erythroid lineages exhibited pronounced hypoplasia. Erythroid
precursors were primarily at intermediate and late maturation
stages, while mature erythrocytes displayed marked
anisopoikilocytosis, including occasional elliptocytes and
tear-drop-shaped cells. Lymphocytes constituted 70.5% of nucleated
cells. No megakaryocytes were identified, and only a few scattered
platelets were observed.
RNA was extracted from bone marrow or peripheral
blood using the nucleic acid extraction reagent from the Lab-Aid
896 Blood Total RNA Kit (Xiamen Zhixuan Biotech Co., Ltd.). The
extracted RNA was reverse transcribed to obtain cDNA using the LF
Enzyme 03 Reverse Transcription Kit (Xiamen Zhixuan Biotech Co.,
Ltd.). The reverse transcription temperature protocol was as
follows: 37°C for 15 min (cDNA synthesis), followed by 85°C for 5
sec (inactivation of reverse transcriptase). The BCR-ABL1 fusion
type of the patient was subsequently determined. The first round of
amplification in the semi-nested PCR was performed using the
corresponding upstream and downstream primers for the fusion type,
with cDNA as the template. The amplification conditions were as
follows: 95°C for 5 min; 95°C for 40 sec, 61°C for 1 min, 72°C for
2 min, for 30 cycles; 72°C for 7 min and hold at 12°C. The
amplification reagent used was from the Phanta Max Super-Fidelity
DNA Polymerase Kit (Vazyme Biotech Co., Ltd.). The first-round
amplification primers were as follows: Type 210 upstream, ABL1-A
5′-GAAGCTTCTCCCTGACATCCGT-3′ (the ABL1-A primer was located on exon
13 of the BCR gene); type 190 upstream, 190-1F
5′-ACCGCATGTTCCGGGACAAAAG-3′ (the 190-1F primer is positioned on
exon 1 of the BCR gene); universal downstream, ABL1-R
5′-TCCACTTCGTCTGAGATACTGGATT-3′.
The second round of amplification in the semi-nested
PCR was performed using the first-round amplification product as
the template. The amplification conditions were as follows: 95°C
for 5 min; 95°C for 40 sec, 62°C for 1 min, 72°C for 1.5 min, for
30 cycles; 72°C for 7 min and hold at 12°C. The amplification
reagent used was the Phanta Max Super-Fidelity DNA Polymerase Kit.
The second-round amplification primers were as follows: ABL1-C,
5′-GCGCAACAAGCCCACTGTCTATGG-3′; ABL1-R,
5′-TCCACTTCGTCTGAGATACTGGATT-3′.
Bidirectional Sanger sequencing (Fig. 3) was performed using the
second-round amplification primers on the second-round products,
and the mutations in the sequencing results were analyzed. The
sequencing primers were as follows: ABL1-C,
5′-GCGCAACAAGCCCACTGTCTATGG-3′; ABL1-R,
5′-TCCACTTCGTCTGAGATACTGGATT-3′.
Quantitative analysis of BCR-ABL1 transcripts
revealed a high disease burden (95.8877%). The high disease burden
was calculated based on qPCR (qPCR) analysis (FAM/BHQ1; DAAN GENE
BCR-ABL1 Quantitative Detection Kit, DAAN GENE Co., Ltd. of Sun
Yat-sen University) of BCR-ABL1 transcript levels normalized to the
reference gene ABL1 the relative quantification was performed using
the comparative Cq method (2−ΔΔCq method) (11,12),
using the formula: BCR-ABL1%=(BCR-ABL1 transcript copies/ABL1
transcript copies) ×100. For the patient, the ratio far exceeded
the National Comprehensive Cancer Network (NCCN) guideline
threshold (>10% on the International Scale) for high disease
burden (13). However, no
specific mutations were detected, possibly as the patient had not
yet progressed to a stage involving kinase domain mutations or due
to the limited sensitivity of Sanger sequencing.
Subsequent next-generation sequencing (NGS) detected
mutations in the ASXL transcriptional regulator 1 (ASXL1) gene,
along with ABL1 TKD mutations, specifically T315I and E459K
(Fig. 4A-C). The variant allele
frequencies (VAFs) for the T315I and E459K mutations were 35 and
22%, respectively, while the ASXL1 mutation exhibited a VAF of 18%.
These alterations were not detectable using conventional
techniques, such as Sanger sequencing and qPCR. The NGS procedure
was performed as follows: Genomic DNA was isolated from peripheral
blood using the Blood Genomic DNA Extraction Kit (Tiangen Biotech
Co., Ltd.), following the manufacturer's protocol. Purity was
assessed using a NanoDrop 2000 spectrophotometer (Thermo Fisher
Scientific, Inc.), and DNA concentration was measured with a Qubit
Fluorometer (Thermo Fisher Scientific). Subsequently, DNA libraries
were prepared using the Watchmaker DNA Library Prep Kit with
Fragmentation (cat. no. WM-503; Watchmaker Genomics). The
constructed libraries underwent quantification by Qubit Fluorometry
and quality assessment using a Fragment Analyzer (Hangzhou Houze
Biotechnology Co., Ltd.). The libraries were then lyophilized into
dry powder using a vacuum centrifugal concentrator (Ningbo Scientz
Biotechnology Co., Ltd.). Hybridization capture was performed
utilizing panel probes and NadPrep Hybrid Capture Reagents [Nanoda
(Nanjing) Biotechnology Co., Ltd.]. After elution, library
enrichment was achieved through PCR amplification using a thermal
cycler (Thermo Fisher Scientific, Inc.). The enriched libraries
underwent a second round of quantification and quality control
using the Qubit Fluorometer and Fragment Analyzer, respectively.
The final library yield was 766 ng, with an average fragment size
of ~480 bp. Quantified by Qubit fluorometry at ~15.32 ng/µl, the
final library concentration was determined to be 48.36 nmol/l
(48.36 nM). Final sequencing was performed on the Salus Pro
platform (Salus BioMed) at a depth of 500×, NGS was performed using
150 bp paired-end sequencing with the following components: Salus
Pro Sequencing Reagent Kit (SRM-PE150-250M; includes sequencing
reagent cartridge, dilution buffer, denaturation buffer,
neutralization buffer and hybridization buffer) and Salus Pro
Sequencing Chip (PRM-PE-250M), supplied by Shenzhen Salus Medical
Technology Co., Ltd.; and the open-source bioinformatics software
bcl2fastq (v2.20.0.422; http://support.illumina.com/downloads/bcl2fastq-conversion-software-v2-20.html),
fastp (0.20.1; http://github.com/OpenGene/fastp), BWA (0.7.8-r455;
http://github.com/lh3/bwa), sambamba
(v0.4.7; http://github.com/biod/sambamba/releases/tag/v0.4.7),
VarDict (1.8.2–2; http://github.com/AstraZeneca-NGS/VarDict) and ANNOVAR
(20211012; http://annovar.openbioinformatics.org/en/latest/),
ensuring high reliability of the results.
Following these findings, the therapeutic regimen
was adjusted to olverembatinib (40 mg, administered every other
day), and allogeneic hematopoietic stem cell transplantation
(allo-HSCT) was proposed as the subsequent step in disease
management. The use of both dasatinib and olverembatinib adheres to
the NCCN International Guidelines for CML (14). The patient had their last check-up
in March 2025 and is currently preparing funds for the
transplant.
Discussion
The present case underscores the notable clinical
challenges in managing CML complicated by the rare coexistence of
T315I and E459K mutations, along with an ASXL1 mutation, which is
strongly associated with disease progression, TKI resistance and a
poor prognosis. The T315I mutation, often referred to as the
‘gatekeeper mutation,’ involves the substitution of threonine with
isoleucine at position 315, leading to the loss of a critical
hydrogen bond and causing steric hindrance at the ATP-binding site;
it is also among the most prevalent mutations in CML, notably
identified in a study of 386 patients who had progressed to the
blastic phase (15). The management
of this mutation remains a major therapeutic challenge, as it
confers resistance to first-line therapy with imatinib and to
second-generation TKIs, including dasatinib and nilotinib (16).
The reported prevalence of the T315I mutation varies
across studies and populations. For instance, it was observed in
21.6% of non-responders in CML cohorts from India (17) and Pakistan (18), in 11.8% in a Western study (19) and in as high as 43.4% in a study
performed by Elsir Khair et al (20). In Chinese CML cohorts, the mutation
rate of T315I is ~5.3% (21), with
markedly higher detection rates among drug-resistant patients
(22). These findings highlight the
regional and cohort-specific variability in T315I prevalence,
emphasizing its critical role as a major resistance mechanism in
CML.
Moreover, multiple studies have consistently
demonstrated that patients harboring the T315I mutation experience
notably worse clinical outcomes compared with those with other
mutations or alternative mechanisms of imatinib resistance
(23). For example, a study from
Pakistan reported that 77.3% (17/22) of T315I-positive patients
showed disease progression, with 58% advancing to the blastic phase
(18). Additionally, the study
noted that patients in the blastic phase were 0.24 times more
likely to develop the mutation compared with those in the chronic
or accelerated phases. Similarly, a study involving 176 patients
with CML demonstrated that individuals with the T315I mutation in
the blastic phase had the worst survival outcomes, with a mean
survival time of only 4 months compared with 22.4 months for
patients in the chronic phase (24).
The E459K mutation in CML, unlike the
well-characterized T315I mutation, is rarely reported and remains
poorly understood. Previous studies have associated E459K with
resistance to dasatinib following imatinib failure (25,26), a
finding further supported by the present case. However, its
clinical relevance, role in disease progression and contribution to
TKI resistance are still underexplored. Using NGS, both a Malaysian
cohort study and research performed in a Chinese population
identified the rare E459K mutation in the BCR-ABL1 TKD (9,27).
E459K mutations have been recognized as emerging in
response to first-generation TKI therapies, such as imatinib, in
patients with CML. Molecular modeling suggests that the E459K
substitution within the α-helix near the TKD replaces a negatively
charged glutamic acid with a positively charged lysine, thereby
disrupting salt bridges and hydrogen bonds with residues such as
R460 and E528. This alteration notably impairs imatinib binding,
which depends on interaction with the inactive kinase conformation
(10). Although bosutinib and
nilotinib, which rely less on the inactive state, initially inhibit
the E459K mutation effectively, their efficacy diminishes over time
as compound mutations (28), such
as the coexistence of T315I and E459K, emerge with enhanced
transforming potential. The presence of E459K exacerbates
T315I-induced conformational changes, increasing steric hindrance
at the ATP-binding pocket and further reducing drug affinity,
thereby complicating therapeutic strategies (29).
Moreover, during treatment, the E459K mutation often
undergoes clonal selection, leading to clonal dominance in some
patients, an event closely associated with loss of response and
treatment failure (30). In current
research on the compound mutations T315I and E459K, the sensitivity
rates of ponatinib for T315I and E459K mutations are 60 and 43%,
respectively. The relevant mechanisms may be associated with the
binding of the drug to the inactive conformation of BCR-ABL1.
Asciminib also shows high sensitivity. Olverembatinib, by targeting
the ATP-binding site of the BCR-ABL1 tyrosine kinase, has a
sensitivity rate as high as 85.3% in patients with T315I mutation.
In patients with the compound mutation of T315I and E459K,
orelabrutinib is also effective, with a sensitivity rate of 33%,
but the specific mechanism has not been elucidated. The relevant
studies (14,31–33)
are summarized in Table III.
 | Table III.Drug sensitivity and resistance
profiles for different mutations. |
Table III.
Drug sensitivity and resistance
profiles for different mutations.
| TKI drugs and
mutation types | Sensitivity | Response rate | Mechanism | (Refs.) |
|---|
| Ponatinib |
|
|
|
|
|
T315I | Sensitive | 60.0% | Binds to the
inactive conformation of the BCR-ABL1 | (30) |
|
E459K | Sensitive | 43.0% | Binds to the
inactive conformation of the BCR-ABL1 | (13) |
| Asciminib |
|
|
|
|
|
T315I | Sensitive | 67% | Allosterically
binds the myristoyl site of BCR-ABL1 | (31) |
|
E459K | Sensitive | Increasing the dose
can achieve a complete response | Binds the myristoyl
pocket of ABL1 | (29) |
| Olverembatinib |
|
|
|
|
|
T315I | Sensitive | 85.3% | Targets the ATP
binding site of BCR-ABL1 tyrosine kinase | (32) |
| T315I +
E459K | Sensitive | 33% | Unreported | (32) |
Mutations in the ASXL1 gene predominantly occur in
exon 12, typically presenting as frameshift or nonsense mutations
(34), and are frequently detected
in acute myeloid leukemia. ASXL1 mutations have also been
identified and extensively investigated in CML cases (35–38).
Furthermore, patients harboring ASXL1 mutations have been reported
to have markedly shorter overall survival compared with those
without such mutations (39–43).
Preclinical studies have demonstrated that ASXL1
mutations are associated with poor responses to chemotherapy
(44). Additionally, these
mutations are associated with genomic instability and an increased
risk of progression to the blast phase in CML (36). Multivariate analysis revealed that
ASXL1 mutation was the sole independent risk factor associated with
inferior event-free survival, with a hazard ratio of 4.25 (95% CI,
1.59–11.35) (45). In the present
case, ASXL1 mutations were detected using NGS, suggesting disease
progression toward the blastic phase.
The BCR-ABL1 TKD mutation status serves a critical
role in guiding clinical decision-making for patients with CML
exhibiting suboptimal responses to TKIs. The failure to perform
conventional cytogenetics may have missed rare additional
chromosomal abnormalities in the present case. However, recent
advancements in NGS-based technologies have enabled the sensitive
detection and quantitative monitoring of BCR-ABL1 TKD mutations.
These methods can identify and quantify sequence variations in
BCR-ABL1 transcripts at abundances as low as 1%, while also
providing insights into the clonal architecture in cases with
multiple mutations (46,47). In the present case, NGS revealed the
coexistence of T315I and E459K mutations, along with an ASXL1
mutation, which were not detected by conventional methods during
earlier evaluations. The application of NGS was crucial in
identifying these low-frequency mutations that traditional assays
might have missed. However, the clinical implementation of NGS for
BCR-ABL1 TKD mutation testing faces several challenges. High costs,
limited accessibility and the lack of standardized guidelines have
impeded its widespread adoption. Moreover, although evidence
supporting NGS-based BCR-ABL1 mutation testing in
treatment-resistant patients with CML is growing, it has not yet
been incorporated into formal clinical recommendations.
Although the present imaging findings and clinical
course suggest extramedullary leukemic infiltration, definitive
pathological confirmation is essential to establish the diagnosis
of blast-phase CML with extramedullary disease, which may have
influenced the accuracy of diagnosis and subsequent treatment
decisions. In the present case, using MRI, a large soft-tissue mass
was observed encasing the affected bone, combined with cortical
disruption and bone destruction, likely indicating leukemic cell
infiltration. The soft tissue encasement of bone is consistent with
previous reports of myeloid sarcoma in CML (48). These imaging findings are associated
with the patient's persistent arm pain and elevated BCR-ABL1
transcript levels.
The patient's history of CML, the presence of a
lesion in the right scapula, the alleviation of pain following TKI
therapy and the subsequent detection of an ASXL1 mutation
collectively suggest that the right scapular lesion represented an
extramedullary manifestation of CML. This extramedullary
involvement is considered to be associated with disease progression
to the blast phase, specifically acute myeloid transformation,
which carries a worse prognosis. This clinical context partially
compensates for the absence of a biopsy-confirmed diagnosis.
Nevertheless, the lack of timely pathological
confirmation remains a limitation. A biopsy could have clarified
the disease stage, guided more aggressive treatment strategies and
facilitated earlier initiation of the transplant process.
Additionally, if the bone lesion had been pathologically confirmed
as CML-related, the timing of initiating olverembatinib treatment
might have been altered. The uncertainty surrounding the lesion's
nature limited diagnostic clarity, potentially delaying the
development of a more personalized and comprehensive treatment
plan.
The U.S. Food and Drug Administration (FDA) and NCCN
guidelines indicate that patients with the T315I mutation in CML
exhibit high resistance to imatinib, dasatinib, nilotinib and
bosutinib (49). Therefore,
ponatinib is recommended as a treatment option for these patients.
According to the NCCN guidelines (V1, 2023), ponatinib demonstrates
a 43% efficacy rate in patients with the E459K mutation.
Olverembatinib exhibits high specificity for the T315I mutation,
with efficacy comparable to ponatinib, but a higher rate of
response in patients with the single T315I mutation (33). Among patients treated with
olverembatinib, the incidence of grade ≥3 thrombocytopenia is
markedly lower compared with that in patients treated with
ponatinib and is not notably associated with dose adjustment
(50). However, in cases involving
compound mutations (T315I + E459K), monotherapy with ponatinib may
be insufficient to fully suppress the expansion of resistant
clones. The compound mutation is relatively rare, and a previous
related study reported two cases of patients with the same compound
mutation (33). Patient 1 received
30 mg oral olverembatinib every other day and achieved a major
molecular response (MMR) after 3 months. However, the patient
voluntarily withdrew from the study at 4 months due to concurrent
breast cancer, with no disease progression observed at withdrawal,
and remained in MMR. Patient 2 received 50 mg oral olverembatinib
every other day and achieved 4.5-log molecular response after 3
months but progressed to blast phase and died at 13 months.
Initially, the present case differed from the literature reports,
as no specific mutation was detected at the beginning, and when the
patient developed resistance to first-generation drugs, treatment
was switched to dasatinib. After confirming the occurrence of
compound mutations, olverembatinib treatment was immediately
initiated, which is in line with the methods recommended in the
literature. Furthermore, although the present patient also
progressed to the accelerated phase (similar to patient 2), they
retained eligibility for transplantation, which is a critical
distinction. While prior case reports focused primarily on
treatment regimens and outcomes, the present study emphasizes
imaging-driven diagnostic insights and a systematic discussion of
therapeutic options, offering pivotal guidance for clinical
decision-making.
Current literature evidence lacks clear guideline
recommendations for patients with the T315I + E459K compound
mutation. Some studies have reported that ponatinib or asciminib
treatment may be attempted (51,52).
Dual targeting with ponatinib and asciminib may overcome compound
mutations and achieve improved therapeutic effects by
simultaneously inhibiting the ATP and myristoyl-binding sites
(53). In CML, overexpression of
BCL-2 is closely associated with TKI resistance. APG-2575, a
selective BCL-2 inhibitor, restores the apoptotic capacity of tumor
cells by targeting the anti-apoptotic protein BCL-2. Preclinical
studies demonstrate that APG-2575 enhances CD8+ T
cell-mediated antitumor immune responses through activation of the
NLRP3 signaling pathway (54). A
study on ponatinib-resistant patients with CML revealed that the
combination of ponatinib and the BCL-2 inhibitor ABT-263 markedly
increased apoptosis sensitivity in primary CML cells (55). Investigations into the efficacy of
third-generation TKIs and novel combination therapies and
preclinical studies of BCL-2 inhibitors (such as APG-2575) combined
with third-generation TKIs warrant exploration in compound-mutated
CML.
In terms of drug selection, olverembatinib was
specifically chosen in the present study, as its molecular
structure was optimized to target the T315I mutation. The drug
exhibits a stronger inhibitory effect on CML harboring the T315I
mutation compared with other TKIs (33). Olverembatinib, as a third-generation
ATP-competitive TKI, has a unique design that achieves broad
coverage of BCR-ABL1 mutations. Through the allosteric adaptation
of its flexible pyrazolo(3,4-d)pyrimidine scaffold to the
ATP-binding pocket, it effectively inhibits a variety of ABL1 TKD
mutations, including T315I. In addition to ABL1, it can target the
Src family and proto-oncogene c-KIT, and its inhibitory spectrum is
notably wider compared with that of traditional TKIs (56). In the present case, the E459K
mutation was located at the SH2-TKD interface, which may disrupt
the auto-inhibitory conformation, increase the basal kinase
activity and induce compensatory activation of Src family kinases
to enhance pathogenicity. Asciminib, on the other hand, achieves
allosteric inhibition by binding to the myristoyl pocket of ABL1
(non-ATP site) and is effective against both wild-type and
T315I-mutant ABL1. However, it lacks the ability to regulate the
Src family or other bypass kinases (57).
Furthermore, compared with asciminib, which is also
effective against T315I-mutated CML, olverembatinib is the first
drug approved in China for treating CML with the T315I mutation and
is supported by more robust evidence (56). Moreover, during the present
patient's illness, asciminib had not yet been approved in China, so
olverembatinib was the best drug choice for the patient. However,
FDA approval allows the use of asciminib for the treatment of
patients with the T315I mutation. A previous study has also shown
that, for patients with the E459K mutation, increasing the dose of
asciminib can partially overcome resistance, although the efficacy
remains limited (30). The present
case not only fills the gap in case reports of dual E459K and T315I
mutations in CML but also provides key evidence for the formulation
of individualized treatment strategies. The first global case
reporting dual E255K and G250E mutations revealed that nilotinib
had limited efficacy against E255K + G250E dual mutations
(BCR-ABL1/ABL1 did not decrease to <0.5%), indicating that
patients with such resistance must prioritize ABL1 TKD mutation
screening (58). The first-line
choice is a broad-spectrum TKI, and the second-line consideration
is a mutation-specific inhibitor (such as asciminib). The present
case, after detecting E459K and T315I mutations by NGS, promptly
changed the treatment strategy. Since asciminib had not been
approved, the medication was adjusted from nilotinib to
olverembatinib to ensure the quality of the patient's
treatment.
Further research is needed to determine whether
asciminib can be considered a superior treatment option for
patients with this dual mutation, or whether combining asciminib
with ponatinib, olverembatinib or other agents offers a viable
therapeutic strategy. Nonetheless, patients harboring compound
mutations typically face poor prognoses, and the use of these drugs
is often part of a bridging strategy. NCCN guidelines prioritize
allo-HSCT for T315I-positive blast-phase CML, given the poor
survival rates associated with TKIs alone (14). The patient in the present study is
currently awaiting transplantation opportunities.
In conclusion, the present case highlights the
notable clinical challenges in managing CML with rare concomitant
mutations such as T315I, E459K and ASXL1. The coexistence of T315I
and E459K may reflect a compound clone with potential synergistic
effects on TKD stability. The coexistence of the mutations T315I
and E459K reported in the present study is extremely rare in the
database, and no studies have been found that directly compare this
compound mutation with individual mutations. Further functional
studies are warranted to clarify whether their co-occurrence
exacerbates therapeutic challenges or represents distinct
sub-clonal evolution pathways. NGS serves a pivotal role in guiding
therapeutic decisions and monitoring disease progression.
Additionally, timely pathological biopsy is essential to confirm
the disease stage, enabling more precise treatment strategies and
facilitating early interventions such as transplantation. Future
research should focus on elucidating the mechanisms underlying rare
compound mutations and developing targeted therapies to improve the
prognosis of high-risk patients with CML. It is recommended to
perform in-depth studies on the mechanisms that favor the emergence
of multiple mutations in the BCR-ABL1 fusion gene, including
selective and therapeutic pressures and clonal dynamics. In
addition, efforts to expand access to advanced diagnostic tools are
required. Moreover, multi-center collaboration is needed to
establish standardized NGS-based mutation screening protocols for
managing TKI-resistant CML.
Acknowledgements
Not applicable.
Funding
The study was supported by a grant from the Taishan Youth
Scholar Foundation of Shandong Province (grant no.
tsqn201812140).
Availability of data and materials
The data generated in the present study may be found
in the NCBI SRA database under accession number SRP584754 or at the
following URL: https://www.ncbi.nlm.nih.gov/sra/?term=SRP584754.
Authors' contributions
XZ designed the study. SH performed the analysis and
interpretation of images. NS performed the analysis and
interpretation of data, and contributed to manuscript drafting and
critical revisions of the intellectual content. XZ and NS confirm
the authenticity of all the raw data. All authors read and approved
the final version of the manuscript.
Ethics approval and consent to
participate
Not applicable.
Patient consent for publication
The patient provided written informed consent for
publication, authorizing the use of their imaging, pathological and
clinical data for publication.
Competing interests
The authors declare that they have no competing
interests.
References
|
1
|
Faderl S, Talpaz M, Estrov Z, O'Brien S,
Kurzrock R and Kantarjian HM: The biology of chronic myeloid
leukemia. N Engl J Med. 341:164–172. 1999. View Article : Google Scholar : PubMed/NCBI
|
|
2
|
Branford S, Rudzki Z, Walsh S, Parkinson
I, Grigg A, Szer J, Taylor K, Herrmann R, Seymour JF, Arthur C, et
al: Detection of BCR-ABL mutations in patients with CML treated
with imatinib is virtually always accompanied by clinical
resistance, and mutations in the ATP phosphate-binding loop
(P-loop) are associated with a poor prognosis. Blood. 102:276–283.
2003. View Article : Google Scholar : PubMed/NCBI
|
|
3
|
Nicolini FE, Corm S, Lê QH, Sorel N,
Hayette S, Bories D, Leguay T, Roy L, Giraudier S, Tulliez M, et
al: Mutation status and clinical outcome of 89 imatinib
mesylate-resistant chronic myelogenous leukemia patients: A
retrospective analysis from the French intergroup of CML
(Fi(phi)-LMC GROUP). Leukemia. 20:1061–1066. 2006. View Article : Google Scholar : PubMed/NCBI
|
|
4
|
Arzoun H, Srinivasan M, Thangaraj SR,
Thomas SS and Mohammed L: The progression of chronic myeloid
leukemia to myeloid sarcoma: A systematic review. Cureus.
14:e210772022.PubMed/NCBI
|
|
5
|
Tsuchiya K, Tabe Y, Ai T, Ohkawa T, Usui
K, Yuri M, Misawa S, Morishita S, Takaku T, Kakimoto A, et al:
Eprobe mediated RT-qPCR for the detection of leukemia-associated
fusion genes. PLoS One. 13:e02024292018. View Article : Google Scholar : PubMed/NCBI
|
|
6
|
Shah NP, Nicoll JM, Nagar B, Gorre ME,
Paquette RL, Kuriyan J and Sawyers CL: Multiple BCR-ABL kinase
domain mutations confer polyclonal resistance to the tyrosine
kinase inhibitor imatinib (STI571) in chronic phase and blast
crisis chronic myeloid leukemia. Cancer Cell. 2:117–125. 2002.
View Article : Google Scholar : PubMed/NCBI
|
|
7
|
Al-Bayati A, Al-Bayti A and Husain V: A
short review about chronic myeloid leukemia. J Life Bio Sci Res.
4:15–19. 2023. View Article : Google Scholar
|
|
8
|
Iqbal Z, Absar M, Akhtar T, Aleem A,
Jameel A, Basit S, Ullah A, Afzal S, Ramzan K, Rasool M, et al:
Integrated genomic analysis identifies ANKRD36 gene as a novel and
common biomarker of disease progression in chronic myeloid
leukemia. Biology (Basel). 10:11822021.PubMed/NCBI
|
|
9
|
Seman ZA, Ahid F, Kamaluddin NR, Sahid
ENM, Esa E, Said SSM, Azman N, Mat WKDW, Abdullah J, Ali NA, et al:
Mutation analysis of BCR-ABL1 kinase domain in chronic myeloid
leukemia patients with tyrosine kinase inhibitors resistance: A
Malaysian cohort study. BMC Res Notes. 17:1112024. View Article : Google Scholar : PubMed/NCBI
|
|
10
|
Vinhas R, Lourenço A, Santos S, Lemos M,
Ribeiro P, de Sousa AB, Baptista PV and Fernandes AR: A novel
BCR-ABL1 mutation in a patient with Philadelphia
chromosome-positive B-cell acute lymphoblastic leukemia.
OncoTargets Ther. 11:8589–8598. 2018. View Article : Google Scholar : PubMed/NCBI
|
|
11
|
Kitamura H, Tabe Y, Ai T, Tsuchiya K, Yuri
M, Misawa S, Horii T, Kawaguchi A, Ohsaka A and Kimura S: A new
highly sensitive real-time quantitative-PCR method for detection of
BCR-ABL1 to monitor minimal residual disease in chronic myeloid
leukemia after discontinuation of imatinib. PLoS One.
14:e02071702019. View Article : Google Scholar : PubMed/NCBI
|
|
12
|
Marin AM, Soares GS, Zanette DL and Aoki
MN: Molecular Biology for BCR-ABL1 quantification for
chronic myeloid leukemia monitorization and evaluation. Arch Cancer
Biol Ther. 2:40–42. 2021.PubMed/NCBI
|
|
13
|
Radich JP, Deininger M, Abboud CN, Altman
JK, Berman E, Bhatia R, Bhatnagar B, Curtin P, DeAngelo DJ, Gotlib
J, et al: Chronic myeloid leukemia, version 1.2019, NCCN clinical
practice guidelines in oncology. J Natl Compr Cancer Netw.
16:1108–1135. 2018. View Article : Google Scholar : PubMed/NCBI
|
|
14
|
Shah NP, Bhatia R, Altman JK, Amaya M,
Begna KH, Berman E, Chan O, Clements J, Collins RH, Curtin PT, et
al: Chronic myeloid leukemia, version 2.2024, NCCN clinical
practice guidelines in oncology. J Natl Compr Cancer Netw.
22:43–69. 2024. View Article : Google Scholar
|
|
15
|
Branford S, Melo JV and Hughes TP:
Selecting optimal second-line tyrosine kinase inhibitor therapy for
chronic myeloid leukemia patients after imatinib failure: Does the
BCR-ABL mutation status really matter? Blood. 114:5426–5435. 2009.
View Article : Google Scholar : PubMed/NCBI
|
|
16
|
Ahn JS, Kim YK, Lee SR, Yu L, Yang DH, Cho
SH, Shim HJ, Bae WK, Lee JJ, Chung IJ, et al: Coexisting with
clonal evolution and BCR-ABL mutant in CML patients treated with
second-generation tyrosine kinase inhibitors predict the
discrepancy of in vitro drug sensitivity. Cancer Res Treat.
42:37–41. 2010. View Article : Google Scholar : PubMed/NCBI
|
|
17
|
Srivastava S and Dutt S: Imatinib mesylate
resistance and mutations: An Indian experience. Indian J Med
Paediatr Oncol. 34:213–220. 2013. View Article : Google Scholar : PubMed/NCBI
|
|
18
|
Kaleem B, Shahab S and Shamsi TS: T315I-a
gatekeeper point mutation and its impact on the prognosis of
chronic myeloid leukemia. Adv Lab Med. 5:412–417. 2024.PubMed/NCBI
|
|
19
|
Soverini S, Colarossi S, Gnani A, Rosti G,
Castagnetti F, Poerio A, Iacobucci I, Amabile M, Abruzzese E,
Orlandi E, et al: Contribution of ABL kinase domain mutations to
imatinib resistance in different subsets of Philadelphia-positive
patients: By the GIMEMA working party on chronic myeloid leukemia.
Clin Cancer Res. 12:7374–7379. 2006. View Article : Google Scholar : PubMed/NCBI
|
|
20
|
Elsir Khair H, Ahmed Mohamed B, Yousef
Nour B and Ali Waggiallah H: Prevalence of BCR-ABL T315I mutation
in different chronic myeloid leukemia patients categories. Pak J
Biol Sci. 25:175–181. 2022. View Article : Google Scholar : PubMed/NCBI
|
|
21
|
Wang J, Zhang Y, Zu Y, Li Z, Li M and Song
Y: Characteristics and clinical outcome of T315I mutation in
Philadelphia chromosome-positive acute lymphoblastic leukemia and
chronic myeloid leukemia. Zhonghua Xue Ye Xue Za Zhi. 37:110–114.
2016.(In Chinese). PubMed/NCBI
|
|
22
|
Chen C, Xu N, Jiang X, Wu W, Zhou X, Liu
L, Huang J, Yin C, Cao R, Liao L, et al: Clinical characteristics
of chronic myeloid leukemia with T315I mutation and the efficacy of
ponatinib. Nan Fang Yi Ke Da Xue Xue Bao. 39:364–368. 2019.(In
Chinese). PubMed/NCBI
|
|
23
|
Jabbour E, Kantarjian H, Jones D, Breeden
M, Garcia-Manero G, O'Brien S, Ravandi F, Borthakur G and Cortes J:
Characteristics and outcomes of patients with chronic myeloid
leukemia and T315I mutation following failure of imatinib mesylate
therapy. Blood. 112:53–55. 2008. View Article : Google Scholar : PubMed/NCBI
|
|
24
|
Nicolini FE, Mauro MJ, Martinelli G, Kim
DW, Soverini S, Müller MC, Hochhaus A, Cortes J, Chuah C, Dufva IH,
et al: Epidemiologic study on survival of chronic myeloid leukemia
and Ph(+) acute lymphoblastic leukemia patients with BCR-ABL T315I
mutation. Blood. 114:5271–5278. 2009. View Article : Google Scholar : PubMed/NCBI
|
|
25
|
Ortiz CA, Alvarez YP, Dongo-Pflucker KL,
Valdivia E, Mendoza Fernández J, Dávila S and Mora-Alférez P:
Mutations in the BCR-ABL1 gene in a peruvian patient with acute
lymphoblastic leukemia resistant to therapy. Rev Fac Cien Med Univ
Nac Cordoba. 74:162–166. 2017.(In Spanish). PubMed/NCBI
|
|
26
|
Takahashi N, Miura M, Kuroki J, Mitani K,
Kitabayashi A, Sasaki O, Kimura H, Imai K, Tsukamoto N, Noji H, et
al: Multicenter phase II clinical trial of nilotinib for patients
with imatinib-resistant or -intolerant chronic myeloid leukemia
from the East Japan CML study group evaluation of molecular
response and the efficacy and safety of nilotinib. Biomark Res.
2:62014. View Article : Google Scholar : PubMed/NCBI
|
|
27
|
Abulaiti D, Tuerxun N, Wang H, Abulizi P,
Zhao F, Liu Y and Hao J: Differences in variants in the structural
domain of BCR-ABL1 kinase between Chinese Han and Minority patients
with chronic myeloid leukemia by sanger sequencing and
next-generation sequencing. Cytogenet Genome Res. 162:201–206.
2022. View Article : Google Scholar : PubMed/NCBI
|
|
28
|
Kim D, Kim DW, Cho BS, Goh HG, Kim SH, Kim
WS, Lee J, Kweon IY, Park SH, Yoon JH, et al: Structural modeling
of V299L and E459K Bcr-Abl mutation, and sequential therapy of
tyrosine kinase inhibitors for the compound mutations. Leuk Res.
33:1260–1265. 2009. View Article : Google Scholar : PubMed/NCBI
|
|
29
|
Zhang H, Zhu M, Li M, Ni D, Wang Y, Deng
L, Du K, Lu S, Shi H and Cai C: Mechanistic insights into
co-administration of allosteric and orthosteric drugs to overcome
drug-resistance in T315I BCR-ABL1. Front Pharmacol. 13:8625042022.
View Article : Google Scholar : PubMed/NCBI
|
|
30
|
Innes AJ, Hayden C, Orovboni V, Claudiani
S, Fernando F, Khan A, Rees D, Byrne J, Gallipoli P, Francis S, et
al: Impact of BCR::ABL1 single nucleotide variants on asciminib
efficacy. Leukemia. 38:2443–2455. 2024. View Article : Google Scholar : PubMed/NCBI
|
|
31
|
Cortes J, Apperley J, Lomaia E, Moiraghi
B, Undurraga Sutton M, Pavlovsky C, Chuah C, Sacha T, Lipton JH,
Schiffer CA, et al: Ponatinib dose-ranging study in chronic-phase
chronic myeloid leukemia: A randomized, open-label phase 2 clinical
trial. Blood. 138:2042–2050. 2021. View Article : Google Scholar : PubMed/NCBI
|
|
32
|
Hughes TP, Mauro MJ, Cortes JE, Minami H,
Rea D, DeAngelo DJ, Breccia M, Goh YT, Talpaz M, Hochhaus A, et al:
Asciminib in chronic myeloid leukemia after ABL kinase inhibitor
failure. N Engl J Med. 381:2315–2326. 2019. View Article : Google Scholar : PubMed/NCBI
|
|
33
|
Jiang Q, Li Z, Qin Y, Li W, Xu N, Liu B,
Zhang Y, Meng L, Zhu H, Du X, et al: Olverembatinib (HQP1351), a
well-tolerated and effective tyrosine kinase inhibitor for patients
with T315I-mutated chronic myeloid leukemia: Results of an
open-label, multicenter phase 1/2 trial. J Hematol Oncol.
15:1132022. View Article : Google Scholar : PubMed/NCBI
|
|
34
|
Fisher CL, Randazzo F, Humphries RK and
Brock HW: Characterization of Asxl1, a murine homolog of Additional
sex combs, and analysis of the Asx-like gene family. Gene.
369:109–118. 2006. View Article : Google Scholar : PubMed/NCBI
|
|
35
|
Boultwood J, Perry J, Zaman R,
Fernandez-Santamaria C, Littlewood T, Kusec R, Pellagatti A, Wang
L, Clark RE and Wainscoat JS: High-density single nucleotide
polymorphism array analysis and ASXL1 gene mutation screening in
chronic myeloid leukemia during disease progression. Leukemia.
24:1139–1145. 2010. View Article : Google Scholar : PubMed/NCBI
|
|
36
|
Makishima H, Jankowska AM, McDevitt MA,
O'Keefe C, Dujardin S, Cazzolli H, Przychodzen B, Prince C, Nicoll
J, Siddaiah H, et al: CBL, CBLB, TET2, ASXL1, and IDH1/2 mutations
and additional chromosomal aberrations constitute molecular events
in chronic myelogenous leukemia. Blood. 117:e198–e206. 2011.
View Article : Google Scholar : PubMed/NCBI
|
|
37
|
Grossmann V, Kohlmann A, Zenger M,
Schindela S, Eder C, Weissmann S, Schnittger S, Kern W, Müller MC,
Hochhaus A, et al: A deep-sequencing study of chronic myeloid
leukemia patients in blast crisis (BC-CML) detects mutations in
76.9% of cases. Leukemia. 25:557–560. 2011. View Article : Google Scholar : PubMed/NCBI
|
|
38
|
Valikhani A, Poopak B, Ferdowsi S, Azizi
Tabesh G, Ghaffari SH, Saraf Kazeruoni E, Rezaei N, Farshchi A and
Amirizadeh N: ASXL1 and JAK2V617F gene mutation screening in
Iranian patients with chronic myeloid leukemia. Asia Pac J Clin
Oncol. 13:e41–e47. 2017. View Article : Google Scholar : PubMed/NCBI
|
|
39
|
Pratcorona M, Abbas S, Sanders MA,
Koenders JE, Kavelaars FG, Erpelinck-Verschueren CA, Zeilemakers A,
Löwenberg B and Valk PJ: Acquired mutations in ASXL1 in acute
myeloid leukemia: Prevalence and prognostic value. Haematologica.
97:388–392. 2012. View Article : Google Scholar : PubMed/NCBI
|
|
40
|
Chou WC, Huang HH, Hou HA, Chen CY, Tang
JL, Yao M, Tsay W, Ko BS, Wu SJ, Huang SY, et al: Distinct clinical
and biological features of de novo acute myeloid leukemia with
additional sex comb-like 1 (ASXL1) mutations. Blood. 116:4086–4094.
2010. View Article : Google Scholar : PubMed/NCBI
|
|
41
|
Gelsi-Boyer V, Trouplin V, Roquain J,
Adélaïde J, Carbuccia N, Esterni B, Finetti P, Murati A, Arnoulet
C, Zerazhi H, et al: ASXL1 mutation is associated with poor
prognosis and acute transformation in chronic myelomonocytic
leukaemia. Br J Haematol. 151:365–375. 2010. View Article : Google Scholar : PubMed/NCBI
|
|
42
|
Yonal-Hindilerden I, Daglar-Aday A,
Akadam-Teker B, Yilmaz C, Nalcaci M, Yavuz AS and Sargin D:
Prognostic significance of ASXL1, JAK2V617F mutations and JAK2V617F
allele burden in Philadelphia-negative myeloproliferative
neoplasms. J Blood Med. 6:157–175. 2015. View Article : Google Scholar : PubMed/NCBI
|
|
43
|
Thol F, Friesen I, Damm F, Yun H,
Weissinger EM, Krauter J, Wagner K, Chaturvedi A, Sharma A,
Wichmann M, et al: Prognostic significance of ASXL1 mutations in
patients with myelodysplastic syndromes. J Clin Oncol.
29:2499–2506. 2011. View Article : Google Scholar : PubMed/NCBI
|
|
44
|
D'Altri T, Wilhelmson AS, Schuster MB,
Wenzel A, Kalvisa A, Pundhir S, Meldgaard Hansen A and Porse BT:
The ASXL1-G643W variant accelerates the development of CEBPA mutant
acute myeloid leukemia. Haematologica. 106:1000–1007. 2021.
View Article : Google Scholar : PubMed/NCBI
|
|
45
|
Bidikian A, Kantarjian H, Jabbour E, Short
NJ, Patel K, Ravandi F, Sasaki K and Issa GC: Prognostic impact of
ASXL1 mutations in chronic phase chronic myeloid leukemia. Blood
Cancer J. 12:1442022. View Article : Google Scholar : PubMed/NCBI
|
|
46
|
Alikian M, Gale RP, Apperley JF and Foroni
L: Molecular techniques for the personalised management of patients
with chronic myeloid leukaemia. Biomol Detect Quantif. 11:4–20.
2017. View Article : Google Scholar : PubMed/NCBI
|
|
47
|
Kohlmann A, Grossmann V, Nadarajah N and
Haferlach T: Next-generation sequencing-feasibility and
practicality in haematology. Br J Haematol. 160:736–753. 2013.
View Article : Google Scholar : PubMed/NCBI
|
|
48
|
Zhang Y, Swoboda DM, Grover A, Nodzon L,
Zhang L and Pinilla-Ibarz J: T315I-mutated myeloid sarcoma. Leuk
Res Rep. 12:1001842019.PubMed/NCBI
|
|
49
|
Andorsky D, Kota V and Sweet K: Exploring
treatment decision-making in chronic myeloid leukemia in chronic
phase. Front Oncol. 14:13692462024. View Article : Google Scholar : PubMed/NCBI
|
|
50
|
Liu T, Wang C, Fu Y, Yang YP and Tan YH:
Olverembatinib combined with inotuzumab ozogamicin in relapsed
refractory Philadelphia chromosome-positive acute lymphoblastic
leukemia: A case report. Medicine (Baltimore). 103:e389852024.
View Article : Google Scholar : PubMed/NCBI
|
|
51
|
Senapati J, Sasaki K, Issa GC, Lipton JH,
Radich JP, Jabbour E and Kantarjian HM: Management of chronic
myeloid leukemia in 2023-common ground and common sense. Blood
Cancer J. 13:582023. View Article : Google Scholar : PubMed/NCBI
|
|
52
|
Nicolini FE, Huguet F, Huynh L, Xu C,
Bouvier C, Yocolly A and Etienne G: A multicenter retrospective
chart review study of treatment and disease patterns and clinical
outcomes of patients with chronic-phase chronic myeloid leukemia in
third-line treatment or with T315I mutation. Cancers (Basel).
15:41612023. View Article : Google Scholar : PubMed/NCBI
|
|
53
|
Amin Muhammad A, Mir Ghazi E, Ali A, Tam
E, Woan K, Chaudhary P, Yaghmour G and Ladha A: Combination therapy
with asciminib and ponatinib as a bridge to brexucabtagene
autoleucel and maintenance in a patient with relapsed refractory
philadelphia positive B-cell acute lymphoblastic leukemia. J Med
Cases. 15:261–266. 2024. View Article : Google Scholar : PubMed/NCBI
|
|
54
|
Luo F, Li H, Ma W, Cao J, Chen Q, Lu F,
Qiu M, Zhou P, Xia Z, Zeng K, et al: The BCL-2 inhibitor APG-2575
resets tumor-associated macrophages toward the M1 phenotype,
promoting a favorable response to anti-PD-1 therapy via NLRP3
activation. Cell Mol Immunol. 21:60–79. 2024. View Article : Google Scholar : PubMed/NCBI
|
|
55
|
Korfi K, Mandal A, Furney SJ, Wiseman D,
Somervaille TCP and Marais R: A personalised medicine approach for
ponatinib-resistant chronic myeloid leukaemia. Ann Oncol.
26:1180–1187. 2015. View Article : Google Scholar : PubMed/NCBI
|
|
56
|
Li Z, Peng D, Deng J, Xiong L, Yin P, Hu
J, Qian C, Yao L, Yin H, Hong M and Wu Q: New ABL1 kinase domain
mutations in BCR::ABL1-positive acute lymphoblastic leukemia.
Cancer Med. 13:e703172024. View Article : Google Scholar : PubMed/NCBI
|
|
57
|
Choi EJ: Asciminib: The first-in-class
allosteric inhibitor of BCR::ABL1 kinase. Blood Res 58(S1).
S29–S36. 2023. View Article : Google Scholar : PubMed/NCBI
|
|
58
|
Li C, Wang Y, Xu D, Zhang P, Ding X, Zhang
N, Xiao M, Huang L and Meng L: E255K and G250E mutation appearing
in a patient with e19a2 chronic myeloid leukemia resistant to
imatinib. Clin Lab. 61:183–186. 2015. View Article : Google Scholar : PubMed/NCBI
|